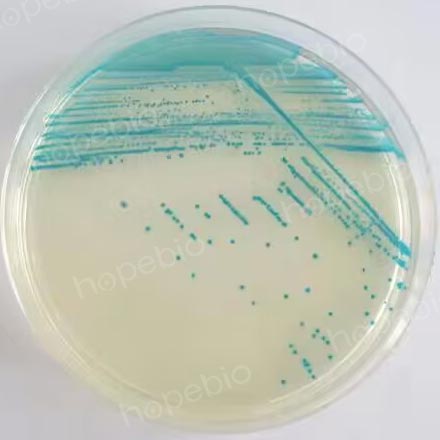
在X-Gal上产生β-半乳糖苷酶的菌落状态

海博微信公众号
海博天猫旗舰店




β-半乳糖苷酶是细菌利用乳糖的关键酶。细菌分解乳糖主要依靠两种酶的作用,一种是β-半乳糖苷酶渗透酶,这种酶作用于细胞膜上,可以让乳糖进入细胞,而另一种就是β-半乳糖苷酶,这种酶位于细胞内,使乳糖分解成半乳糖和葡萄糖。
同时具有上述两种酶的细胞,可以在24-48h内发酵乳糖,同时缺乏上述两种酶的细菌,不能分解乳糖。而部分细菌只具有β-半乳糖苷酶(如宋内志贺氏菌、亚利桑那沙门氏菌),而不具有β-半乳糖苷酶渗透酶,因此乳糖进入细胞很慢,宏观表现则为迟缓发酵乳糖(通常需要3-7天)。在《GB4789.5-2012食品安全国家标准 食品微生物学检验 志贺氏菌检验》中,提供了两种检测细菌是否含有β-半乳糖苷酶的方法。
1. 液体法(ONPG法)
所有乳糖快速发酵和迟缓发酵的细菌,都可以快速水解邻硝基酚-β-D-半乳糖苷(O-nitrophenyl-β-D-galactopyranoside,ONPG)而生成黄色的邻硝基酚。因而利用ONPG可以快速检测迟缓发酵乳糖的菌株。
培养基成分:
|
ONPG |
60.0mg |
|
0.01mol/L磷酸钠缓冲液(PH7.3-7.7) |
10.0ml |
|
1%蛋白胨水(PH7.3-7.7) |
30.0ml |
制法:
将ONPG溶于缓冲液内,加入蛋白胨水,以过滤法除菌,分装于10mm×75mm试管内,每管0.5mL,用橡皮塞塞紧。
也可直接购买我司安瓿瓶装的ONPG生化管 点击查看。
试验方法:
挑取培养物一满环接种,于36℃±1℃培养1h-3h和24h观察结果。如果β-半乳糖苷酶产生,则于1h-3h变黄色,如无此酶则24h不变色。ONPG在固体培养基中分解后的显色终产物会大面积扩散,因此只适用于液体培养基。
2. 平板法(X-Gal法)
利用5-溴-4-氯-3-吲哚-β-D-半乳糖苷(X-Gal)作为显色底物,如果细菌含有β-半乳糖苷酶,则分解显色底物,平板上的培养物变蓝色。如不含此酶,则菌落呈无色或不透明色。
培养基成分:
|
蛋白胨 |
20.0g |
|
氯化钠 |
3.0g |
|
5-溴-4-氯-3-吲哚-β-D-半乳糖苷(X-Gal) |
200.0mg |
|
琼脂 |
15.0g |
|
蒸馏水 |
1000.0ml |
制法:
将各成分加热煮沸于1L蒸馏水中,冷却至25℃左右校正pH至7.2±0.2,115℃高压灭菌10min,倾注平板避光冷藏备用。
试验方法:
挑取培养物接种于平板,划线或点种皆可,于36℃±1℃培养18-24h观察结果。如果有β-半乳糖苷酶产生,则平板上菌落呈蓝色。如不含此酶,则菌落呈无色或不透明色。培养48h-72h后,有部分转为淡粉色。
X-Gal在液体和固体里中检测β-半乳糖苷酶的活性比其他显色或荧光底物更有效。
相关产品:
相关标准:
注:本文属海博生物原创,未经允许不得转载。
上一篇:含酶TSA平板效果验证试验
下一篇:艰难梭菌的活化与保存
| 相关文章: | ||
